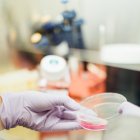
drew-hays-tGYrlchfObE-unsplash

Noticias del 27 de junio de 2019

Lo último


¡Paciencia!
Guido Gómez Mazara

Sobre la Sentencia TC/0129/26
Eduardo Jorge Prats

Mes de la Patria supera los anteriores
MIGUEL PINEDA LÓPEZ

El deporte nos une como nación
FERNANDO RODRÍGUEZ C.